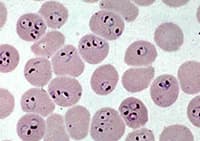
falciparum
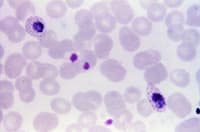
ovale
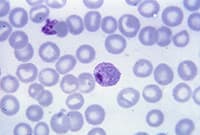
vivax
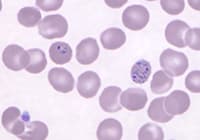
knowlesi

- Private & confidential service
- Genuine medication
- All-inclusive service - No hidden fees
- Next day delivery
Malaria
Start your consultation

- Taken as malaria prevention
- Free next day delivery
- Taken daily throughout your trip

- Protects against malaria
- One single daily dose
- Free next day delivery
Malaria
Malaria is a well-known disease, spread by the bite of a mosquito in predominantly tropical and subtropical regions. It poses one of the biggest risks to people travelling abroad, with approximately 1,500 Brits contracting it annually.
There are preventative medications, such as Malarone and Doxycycline, that are proven to safeguard travellers in malaria-endemic areas. These are available to purchase from HealthExpress, once an online consultation has been completed and approved.
Topics
What is malaria?
Malaria is a serious and sometimes fatal tropical blood-disease caused by a parasite called plasmodium that is transferred by the anopheles mosquito. Malaria is most commonly contracted through a mosquito bite when visiting foreign, tropical countries.
When a person is bitten by a mosquito, the malaria parasite enters the bloodstream and quickly migrates to the liver. There it multiplies, before being released throughout the body.
At this point, the parasite begins invading red blood cells, multiplying within them until they burst- this in turn accelerates the process. This does not take a long time to occur and usually results in the symptoms associated with malaria such as a heavy fever, fatigue, vomiting and diarrhoea.
parasite starts reproducing rapidly in liver. Some parasites lie dormant in the liver and become activated years after initial infections. Gets into the blood stream, attaches and enters red blood cells. Further reproduction occurs. Infected red blood cells brust, infecting other blood cells. This repeating cycle depletes the body of oxygen and also causes fever. The cycle coincides with malaria's fever and chills. After release, a dormant version of malaria travels through the host's blood stream, waiting to be ingested by another mosquito to carry it to a new host. dormant parasites
What causes malaria?
Malaria was first discovered as a harmful blood parasite in 1880. Caused by the parasite 'plasmodium', a small, single-cell organism, it is spread to humans via the bite of infected mosquitos.
There are over 100 varieties of plasmodium parasites, but only five are identified to commonly infect humans and have various effects on the carrier.
|
|
|
|
|
What are the symptoms of malaria?
The first sign of malaria is usually a flu-like fever, and the incubation period (the time of infection until the appearance of symptoms) for each strain generally differs:
- 9 to 14 days for P. falciparum.
- 12 to 18 days for P. vivax and P. ovale.
- 18 to 40 days for P. malariae.
- 11 to 12 days for P. knowlesi.
During the early stages symptoms that can be experienced are very similar to that of severe influenza.
 Chills
Chills Headaches
Headaches Muscle aches
Muscle aches
 Fatigue
Fatigue Nausea
Nausea Diarrhoea
Diarrhoea
 Vomiting
Vomiting
Because of the loss of red blood cells, malaria can also lead to jaundice and anaemia, however the vast majority of sufferers are treated before this stage. Certain cases have also reported back pain and an enlarged spleen.
The plasmodium falciparum, being the most dangerous of the malaria parasites, can potentially cause more severe symptoms; for example, kidney failure, seizures, reduced mental capacity and coma.
Where is malaria most common?
Malaria is most common in hot and humid climates, where the anopheles mosquito lives and thrives. Hotspots in the world where there is a high risk of malaria include:
- North Africa
- The Middle East
- South and Central Asia
- Sub-Saharan Africa
- Central and South America
- The Caribbean
- Papua New Guinea, the Solomon Islands, and Vanuatu (Oceania)
The fatal plasmodium falciparum malaria parasite is more prevalent in Africa, but is also found in Latin America, Asia and Oceania.
How can malaria be prevented?
There are a number of basic steps you should take when attempting to prevent malaria.
- Mosquito repellent creams will help to prevent bites by repelling mosquitoes. The most effective repellents contain DEET (diethyltoluamide)
- Prescribed medication to prevent malaria
- Products that contain eucalyptus oil can also be effective
- There are also certain sunscreens that can prevent against insect bites
- A mosquito net treated with insecticide is also highly recommended for when you are sleeping, as mosquitoes are most active when it's dark
How is malaria treated?
While taking simple precautions is important, the most successful way to prevent infection is with malaria tablets. There currently isn't a vaccine available to prevent malaria; therefore prescription medication is the best option. Malaria tablets work by preventing the parasites' ability to reproduce, allowing your body to neutralise the infection.
All antimalarial drugs need to be started before you leave for your destination, and also need to be taken for a short period after you return. Malaria can sometimes take 10 - 15 days to cause symptoms after the infection. In rare cases, it can lie dormant for more than a year, although fortunately the most dangerous strain is not known to do this.
Which treatment you need will depend largely on where you are travelling. For lower risk areas such as India, a treatment of Paludrine & Avloclor is recommended. For higher risk areas, either Doxycycline or Malarone can be prescribed. Both of these treatments are considered to be effective against the most dangerous form of the virus.
What malaria treaments are available?
Malaria has the potential to be very serious, as it is regarded as the most dangerous disease on the planet, therefore prophylactic treatment is important if you are travelling to an area where malaria is a risk. Beginning a course of medication before travelling can easily prevent malaria. The antimalarials we have available, which are approved by UK qualified doctors, are Doxycycline and Malarone. These Malaria treatments are clinically proven to effectively prevent Malaria and can be ordered quickly and securely online by completing our free, simple online consultation. These treatments can be shipped by free next day delivery to ensure that you receive your medication before beginning your travels.
What are some facts about malaria?

3 simple steps to get you started